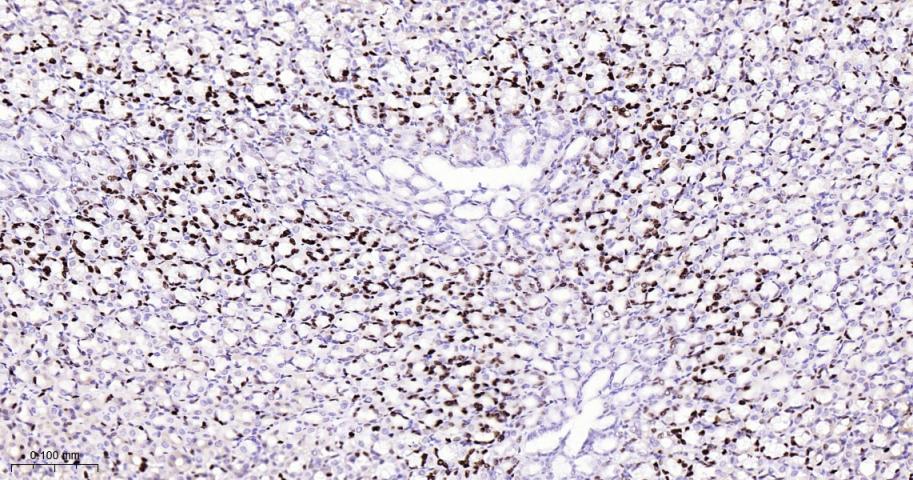
微小染色体维持缺陷蛋白2重组兔单抗

微小染色体维持缺陷蛋白2重组兔单抗
Rrmab?兔单抗

货号:bsm-63311R
产品详情
相关标记
相关产品
相关文献
常见问题
概述
产品编号
bsm-63311R
产品类型
重组兔单抗、mIHC精品抗体
英文名称
MCM2 Recombinant Rabbit mAb
中文名称
微小染色体维持缺陷蛋白2重组兔单抗
英文别名
BM28; CCNL1; CDCL1; D3S3194; DFNA70; MITOTIN; cdc19; Mcmd2; mKIAA0030; MCM2_HUMAN; MCM2; Minichromosome maintenance protein 2 homolog; Nuclear protein BM28; 3.6.4.12; KIAA0030; MCM2_MOUSE;
抗体来源
Rabbit
免疫原
A synthesized peptide derived from human MCM2: 41-65
亚型
IgG
性状
Liquid
纯化方法
affinity purified by Protein A
克隆类型
Recombinant
克隆号
7F5
理论分子量
102 kDa
检测分子量
125 kDa
储存液
10mM phosphate buffered saline(pH 7.4) with 150mM sodium chloride, 0.05% BSA, 0.02% Proclin300 and 50% glycerol.
SWISS
Gene ID
保存条件
Store at 4℃ for short term. Store at -20℃ for long term. Avoid repeated freeze/thaw cycles.
注意事项
This product as supplied is intended for research use only, not for use in human, therapeutic or diagnostic applications.
数据库链接
产品介绍
微小染色体维持缺陷蛋白2又称微型染色体维持蛋白2或丝裂蛋白,MCM-2是细胞周期阶段的特异性标志物,在进入细胞周期的细胞中均有表达,在细胞的增值、分化中起到一定的作用
背景资料
Acts as a component of the MCM2-7 complex (MCM complex) which is the replicative helicase essential for 'once per cell cycle' DNA replication initiation and elongation in eukaryotic cells. Core component of CDC45-MCM-GINS (CMG) helicase, the molecular machine that unwinds template DNA during replication, and around which the replisome is built.

产品应用
| 应用 | 已检合格种属 | 预测种属 | 推荐稀释比例 |
|---|---|---|---|
| WB | Human, Mouse, Rat | 1:1000-2000 | |
| IHC-P | Human, Mouse, Rat | 1:200-800 | |
| IHC-F | Human, Mouse, Rat | 1:200-800 | |
| IF | Human, Mouse, Rat | 1:200-800 | |
| Flow-Cyt | Human | Mouse, Rat | 1:50-200 |
| ICC/IF | Human | Mouse, Rat | 1:100-200 |
交叉反应
交叉反应: Human, Mouse, Rat
相关产品
暂无相关产品
靶标
基因名
MCM2
蛋白名
DNA replication licensing factor MCM2
亚基
Component of the MCM2-7 complex. The complex forms a toroidal hexameric ring with the proposed subunit order MCM2-MCM6-MCM4-MCM7-MCM3-MCM5. Interacts with KAT7 and DBF4. May interact with MCM10.
亚细胞定位
Nucleus (Probable).
翻译后修饰
Phosphorylated on Ser-108 by ATR in proliferating cells. Ser-108 proliferation is increased by genotoxic agents. Ser-40 is mediated by the CDC7-DBF4 and CDC7-DBF4B complexes, while Ser-53 phosphorylation is only mediated by the CDC7-DBF4 complex. Phosphorylation by the CDC7-DBF4 complex during G1/S phase is required for the initiation of DNA replication.
相似性
Phosphorylated on Ser-108 by ATR in proliferating cells. Ser-108 proliferation is increased by genotoxic agents. Ser-40 is mediated by the CDC7-DBF4 and CDC7-DBF4B complexes, while Ser-53 phosphorylation is only mediated by the CDC7-DBF4 complex. Phosphorylation by the CDC7-DBF4 complex during G1/S phase is required for the initiation of DNA replication.
功能
Acts as component of the MCM2-7 complex (MCM complex) which is the putative replicative helicase essential for 'once per cell cycle' DNA replication initiation and elongation in eukaryotic cells. The active ATPase sites in the MCM2-7 ring are formed through the interaction surfaces of two neighboring subunits such that a critical structure of a conserved arginine finger motif is provided in trans relative to the ATP-binding site of the Walker A box of the adjacent subunit. The six ATPase active sites, however, are likely to contribute differentially to the complex helicase activity. Required for the entry in S phase and for cell division.
标记抗体
暂无标记数据
同靶标产品
暂无同靶标产品
相关文献
提示: 发表研究结果有使用 bsm-63311R 时请让我们知道,以便我们可以引用参考文章。作为回馈,资料提供者将获得我们送上的小礼品。
暂无相关文献
常见问题
暂无常见问题